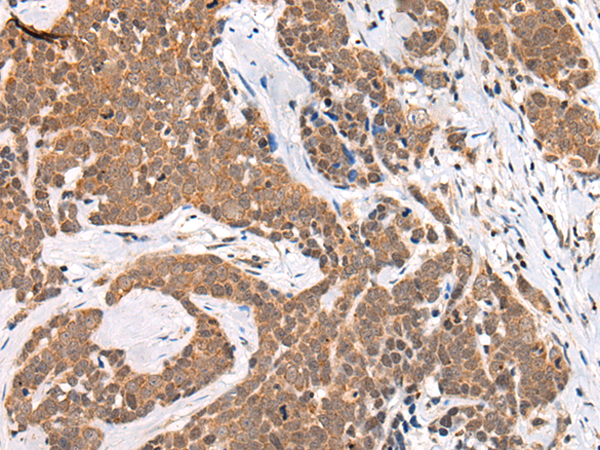

|
Background: |
CHAMP1 (chromosome alignment maintaining phosphoprotein 1), also known as ZNF828 or C13orf8, is a 812 amino acid protein containing one C2H2-type zinc finger. CHAMP1 is required for the proper alignment of chromosomes during metaphase, undergoing CDK1-dependent phosphorylation at multiple sites during mitosis. The phosphorylation counteracts the negative chromosomal alignment regulation of the zinc-finger domain of CHAMP1. One region of CHAMP1, the FPE region, is responsible for spindle and kinetochore localization, which is essential for proper chromosome alignment. CHAMP1 interacts with MAD2L2, PGOZ, CBX1, CBX3 and CBX5, and may recruit CENPE and CENPF to the kinetochore. The CHAMP1 gene is located on chromosome 13 and is conserved in chimpanzee, Rhesus monkey, dog, cow, mouse, rat and chicken. |
|
Applications: |
ELISA, IHC |
|
Name of antibody: |
CHAMP1 |
|
Immunogen: |
Synthetic peptide of human CHAMP1 |
|
Full name: |
chromosome alignment maintaining phosphoprotein 1 |
|
Synonyms: |
CAMP; CHAMP; MRD40; ZNF828; C13orf8 |
|
SwissProt: |
Q96JM3 |
|
ELISA Recommended dilution: |
5000-10000 |
|
IHC positive control: |
Human colorectal cancer and human thyroid cancer |
|
IHC Recommend dilution: |
30-150 |

購(gòu)物車(chē)
購(gòu)物車(chē) 幫助
幫助
 021-54845833/15800441009
021-54845833/15800441009
